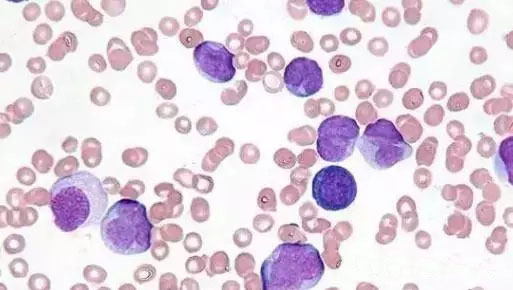
640.webp.jpg

央视网消息:这两天,一名白血病女童的父亲写的文章刷爆朋友圈,引起了公众广泛关注和争论。然而关于白血病,很多人并不是很了解,许多人对其的认识都是源于电视剧,在大部分人眼中,“白血病”三个字显得异常恐怖。
那白血病都是不治之症吗?它到底是怎样一种疾病?下面就一起来了解一下。
白血病患者的血是白色的吗?
No,白血病患者的血液仍是红色。
“白血病”这个名称并不是对于患者血液颜色的描述,而是指患者血液中出现了大量异常的白细胞。
△白血病细胞(资料图)
在正常情况下,我们体内的白细胞、红细胞和血小板三者维持在相对正常的范围里。但是,一旦发生白血病,这种稳态便会被打破,异常的白细胞肆意生长,抑制了正常的血细胞生成。这就像一片肥沃的土地原本都该种水稻,但是水稻的某些种子出现了异常,长出了一大片杂草。白血病细胞就如同这些杂草,它们不单单消耗了营养,还会影响正常细胞,造成其数量明显减少,从而导致各种症状。
装修污染会导致白血病吗?
白血病发病一般认为有三大因素
至今为止,白血病的确切病因还没有找到,一般认为,有三大类影响因素:
①毒物接触。目前已经被证明会导致白血病的化学物质是苯及其衍生物,多存在于橡胶、染料、油漆中。
②辐射。整个身体或部分躯体受到中等剂量或大剂量辐射后,可能诱发白血病。比如核电泄漏,就被证明可致使附近居民患上白血病;
③一些特定病毒。这类病毒在生活中极为少见,因此不必太过担心。
对很多人关心的遗传因素,只能说,基因是否会导致白血病的易感性,尚处在观察阶段,并没有确切证据证明白血病具有明显的家族倾向性。家人同患白血病的情况,更多归因于他们相同的生活环境中存在白血病诱发因素。
近几年白血病发病率上升了吗?
No,白血病的发病率多年来没有太大变化。
很多人觉得现在得白血病的人多了,其实并不是这样,流行病学调查显示,白血病的发病率多年来没有太大变化,大约3~4人/10万人口。

之所以会产生增加的错觉,主要源于两个原因,一是过去很多人得了病认为治不了,干脆就不治了;二是过去医学上对白血病的诊断没有现在准确,一些出现发烧、贫血症状的患者被漏诊了。
白血病患者都是小孩吗?
No,儿童和成年人都会患白血病。
平日大家经常在媒体报道中看到“父母卖房救助白血病女儿”或者像此次刷屏朋友圈的“卖文救白血病女儿”之类的报道,看多了许多人不免会觉得白血病是儿童易患病。然而事实却是:成年人,尤其是老年人患白血病的更多。
据统计,2014年全美国0~19岁少年儿童共有3810例初发白血病,而新发成人白血病病例却高达52380例。白血病的总体发病率和其他肿瘤一样,都是随着年龄增大而逐渐升高的。
所有白血病都是绝症吗?
No,白血病并非都是绝症。
随着医学发展,对于白血病的治疗手段也层出不穷,获得治愈的患者也越来越多。目前白血病的治疗方法主要包括以下三种:静脉化疗、骨髓移植、靶向治疗。
急性白血病恶性程度高,病情变化快,危及患者生命,需要尽快治疗。

△静脉化疗资料图
40余年前,人们就开始使用化疗的方法治疗白血病,时至今日,急性白血病的基础治疗方案仍然是静脉化疗。不过化疗虽能够使疾病在短期内得到控制,却难以除根。
自1990年起,骨髓移植也得到了广泛应用。截止2013年,全球范围内已经有超过100万人接受了骨髓移植治疗。相比单纯化疗,接受骨髓移植后的疗效明显改善,超过半数的患者能获得治愈,而且随着医疗技术的进步,配型已不局限于捐、受双方的全相合,父母与子女、亲表兄妹间的半相合移植情况也越来越多,再加上脐带血的应用,给移植提供了更多选择。因此,现在缺乏供体的情况越来越少。

△骨髓采集资料图
此外,更令人欣喜的是,靶向治疗逐渐进入人们视线。所谓靶向治疗就是针对产生异常的「种子」,仅仅杀伤它们,而不损害其他正常细胞。急性白血病中的一个类型——急性早幼粒细胞白血病目前已经有了成熟的靶向治疗方案。
而慢性白血病疾病进展较慢,一般不需要静脉化疗。其中的慢性粒细胞白血病,目前也可以通过口服靶向药物来控制疾病的发展,延长患者的生存时间。慢性淋巴细胞白血病则由于早期治疗并不能改善长期生存,反而会影响生活质量,所以可以观察随访,直到疾病进展时再治疗。
如何尽可能预防白血病?
避免毒物接触是关键。
主要是避免毒物接触,尤其要注意避免苯污染。家装中,油漆中往往含有大量的苯及苯系物,因此装修竣工后一定要找正规的检测机构对室内空气进行检测,早检测,早知道,早预防!
一旦出现不明原因的出血、发烧、关节痛、头晕等症状,最好到医院进行检查。此外,注意饮食卫生,不要滥用药物,尽量少染发。


